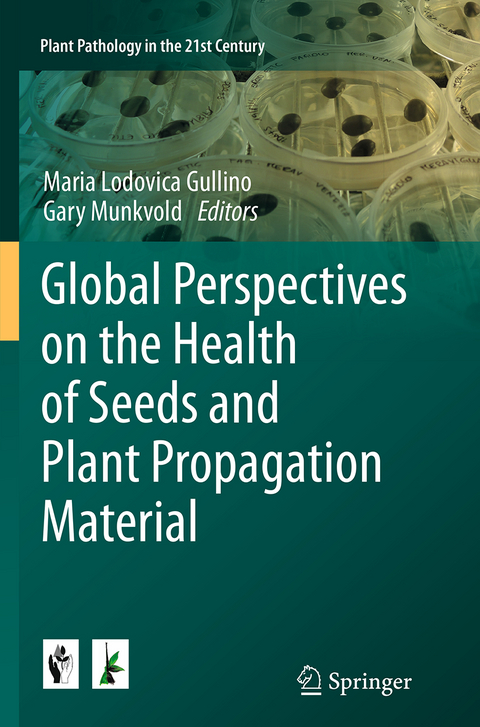
Global Perspectives on the Health of Seeds and Plant Propagation Material -

Global Perspectives on the Health of Seeds and Plant Propagation Material
Seiten
2016
|
Softcover reprint of the original 1st ed. 2014
Springer (Verlag)
9789402406979 (ISBN)
Springer (Verlag)
9789402406979 (ISBN)
This volume continues the series of books on “Plant Pathology in the 21st Century”, and contains the papers given at the 10th International Congress of Plant Pathology (ICPP 2013) held in Beijing, August 25-30, 2013 concerning seed health.
Many pathogens are transmitted throughout infected seeds and propagation material .The fact that propagation material production is very much concentrated in few establishments, favors the quick spread of new diseases throughout seed commercialization. This phenomenon is very much accelerated in a globalized system.
The book covers case studies of contamination, aspects of detection and diagnosis as well as disease management strategies, with special emphasis towards seed treatments with unconventional products.
This book will be useful for all plant pathologists as well as students in advanced courses.
Many pathogens are transmitted throughout infected seeds and propagation material .The fact that propagation material production is very much concentrated in few establishments, favors the quick spread of new diseases throughout seed commercialization. This phenomenon is very much accelerated in a globalized system.
The book covers case studies of contamination, aspects of detection and diagnosis as well as disease management strategies, with special emphasis towards seed treatments with unconventional products.
This book will be useful for all plant pathologists as well as students in advanced courses.
I. General aspects.- 1. Seed Pathology Progress in Academia and Seed Industry.- 2. Global Standards in Seed Health Testing.- 3. Seed-borne pests and phytosanitary issues: the role of EPPO.- 4. Seed-borne fungal pathogens of leafy vegetable crops.- II. Detection.- 5. Technical challenges for specific, sensitive detection of seed-borne bacterial pathogens.- 6. Improved detection and monitoring of seed-borne fungal plant pathogens in Europe.- III. Seed treatments.- 7. Benefits of chemical seed treatments on crop yield and quality.- 8. Non-chemical Seed Treatment in the Control of Seed-borne Pathogens.- 9. Chemical and non-chemical seed dressing for leafy vegetable crops.
| Erscheinungsdatum | 01.09.2016 |
|---|---|
| Reihe/Serie | Plant Pathology in the 21st Century ; 6 |
| Zusatzinfo | 5 Illustrations, color; 12 Illustrations, black and white; X, 136 p. 17 illus., 5 illus. in color. |
| Verlagsort | Dordrecht |
| Sprache | englisch |
| Maße | 155 x 235 mm |
| Themenwelt | Naturwissenschaften ► Biologie ► Botanik |
| Weitere Fachgebiete ► Land- / Forstwirtschaft / Fischerei | |
| ISBN-13 | 9789402406979 / 9789402406979 |
| Zustand | Neuware |
| Informationen gemäß Produktsicherheitsverordnung (GPSR) | |
| Haben Sie eine Frage zum Produkt? |
Mehr entdecken
aus dem Bereich
aus dem Bereich
Gefäßpflanzen: Grundband
Buch | Hardcover (2021)
Springer Spektrum (Verlag)
CHF 62,95


